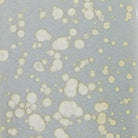

BARRON Table Lamp
110% Price Guarantee
You know you are getting the best Canadian Landed Price at Canada Light Shop. If you find the same product advertised for less by one of our Canadian competitors within 30 days of your purchase, we will gladly match the lower price + 10% of the difference. Click here for more information.

110% price match guarantee with no hidden fees
You know you are getting the best Canadian Landed Price at Canada Light Shop. If you find the same product advertised for less by one of our Canadian competitors within 30 days of your purchase, we will gladly match the lower price + 10% of the difference.

Speak with our ALA trained and certified lighting experts
Whether it's selecting the best designs or solving lighting challenges, our accredited American Lighting Association specialists are here to help with every aspect of your lighting needs. From lighting design to product advice, contact us for expert guidance and solutions.

Canada's largest selection of premium lighting brands
Canada Light Shop is Canada's premier online destination for lighting solutions. Our extensive inventory features a diverse range of renowned brands, offering unparalleled choice and quality to meet your lighting needs.